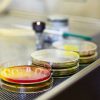

(د ب أ)- كشفت اللجنة المنظمة لبطولة كأس العالم للناشئين تحت 17 سنة والمقرر إقامتها بالإمارات هذا العام،عن الشعار الرسمي للبطولة، والذي استوحت تصميمه من صدفة اللؤلؤ المزين بألوان العلم الإماراتي.
وقال يوسف السركال رئيس اللجنة المحلية المنظمة للبطولة،رئيس اتحاد الإمارات لكرة القدم أن تصميم شعار البطولة تم بالتنسيق مع الاتحاد الدولي لكرة القدم،وهو مستمد من التراث الإماراتي.
وأضاف في حفل أقيم مساء الثلاثاء (5 مارس 2013) بأبو ظبي أن "الإمارات حققت نجاحات كبيرة في تنظيم بطولات كبرى،وقادرة على تنظيم هذه البطولة بالصورة المثلى التي تليق باسم الإمارات".
وأشار السركال إلى أن المنتخب الإماراتي للناشئين تم إعداده بصورة جيدة ليخوض البطولة ويقدم مستوى مشرفا.
ومن المقرر أن تنطلق البطولة في 17 تشرين أول/أكتوبر وتستمر حتى يوم 8 تشرين ثان/نوفمبر المقبلين،ويشارك فيها 24 منتخبا وستقام مبارياتها في مدن أبو ظبي ودبي والعين والشارقة ورأس الخيمة والفجيرة.